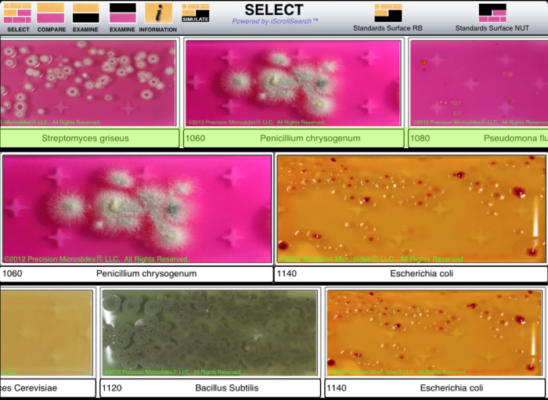

Nutrient TTC Dipslide
See Product Documentation tab for a complete instructional download with information including test procedures, storage, incubation, and reading the results.
BioPaddlesLite iTunes App
The BioPaddlesLite App is a free app that helps you presumptively identify bacteria and mold colonies growing on your dipslide. By selecting the agar you used and the microhabitat you tested, the app will narrow down results from over 80 standard images. Compare your dipslide growth to the images for a presumptive identification, or use the grid for counting colonies. A more robust version is available for $5.99. The full BioPaddles app includes a library of over 250 standard images, as well as a camera function and reporting feature.
Disclaimer: Precision Laboratories products are not approved for use as medical devices. Products and product information is for informational purposes only and not intended for use to diagnose, treat, cure or prevent any medical condition. Consult a medical doctor when needed.
SKU 1: M-NUT-NUT-4 (4 Dipslides)
SKU 2: M-NUT-NUT-10 (10 Dipslides)
SKU 3: M-NUT-NUT-100 (100 Dipslides)
Paddle Dimensions: 1.167” (W) x 3.25” (H) [30mm (W) x 83mm (H)]
Box Dimensions: 13″ x 11″ x 5″ [33 cm x 27.9 cm x 12.7 cm] (100-pack box), 4.5″ x 3.5″ x 3.5″ [11.4 cm x 8.9 cm x 8.9 cm] (4-pack box), 6.34″ x 2.56″ x 4.425″ [16.1 cm x 6.5 cm x 11.2 cm] (10-pack box)
Weight: 0.4 lbs [0.2 kg] (4-pack), 0.6 lbs [0.3 kg] (10-pack), 6.2 lbs [2.8 kg] (100-pack)
Shelf-Life: 6-9 Months
Label: Customizable Label
Other: Flexible paddle for surface testing., Longer shelf-life than contact plates.














